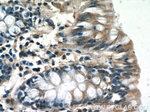
POM121 Antibody in Immunohistochemistry (Paraffin) (IHC (P))
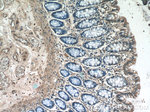
POM121 Antibody in Immunohistochemistry (Paraffin) (IHC (P))

Search
Proteintech
POM121 Polyclonal Antibody
{{$productOrderCtrl.translations['antibody.pdp.commerceCard.promotion.promotions']}}
{{$productOrderCtrl.translations['antibody.pdp.commerceCard.promotion.viewpromo']}}
{{$productOrderCtrl.translations['antibody.pdp.commerceCard.promotion.promocode']}}: {{promo.promoCode}} {{promo.promoTitle}} {{promo.promoDescription}}. {{$productOrderCtrl.translations['antibody.pdp.commerceCard.promotion.learnmore']}}
产品信息
15645-1-AP
种属反应
已发表种属
宿主/亚型
分类
类型
抗原
偶联物
形式
浓度
规格
纯化类型
保存液
内含物
保存条件
运输条件
产品详细信息
15645-1-AP do well in identifying the nuclear envelope in immunofluorescence experiments.
Immunogen sequence: SQSLHTAVP TATSSSAADF SGFGSTLATS APATSSQPTL TFSNTSTPTF NIPFGSSAKS PLPSYPGANP QPAFGAAEGQ PPGAAKPALA PSFGSSFTFG NSAAPAAAPT PAPPSMIKVV PAYVPTPIHP IFGGATHSAF GLKATASAFG APASSQPAFG GSTAVFFGAA TSSGFGATTQ TASSGSSSSV FGSTTPSPFT FGGSAAPAGS GSFGINVATP GSSTTTGAFS FGAGQSGSTA TSTPFAGGLG QNALGTTGQS TPFAFNVSST TESKPVFGGT ATPTFGLNTP APGVGTSGSS LSFGASSAPA QGFVGVAPFG SAALSFSIGA GSKTPGARQR LQARRQHTRK K (635-984 aa encoded by BC008794)
靶标信息
POM121 (POM121 membrane glycoprotein), also known as POM121A (nuclear envelope pore membrane protein POM 121A), NUP121 (nucleoporin Nup121) or pore membrane protein of 121 kDa, is a 1,249 amino acid single-pass membrane protein that exists as three alternatively spiced isoforms and belongs to the POM121 family. Encoded by a gene that maps to human chromosome 7q11.23, POM121 is highly conserved and localizes to nucleus membrane and endoplasmic reticulum membrane. An essential component of the nuclear pore complex (NPC), POM121 is mandatory for nuclear envelope formation and may play a role in biogenesis of the NPC. POM121 associates with the central spoke ring complex and is involved in anchoring components of the pore complex to the pore membrane by way of its F-X-F-G repeat-containing domain. POM121 overexpression induces the formation of cytoplasmic annulate lamellae (AL).
仅用于科研。不用于诊断过程。未经明确授权不得转售。
生物信息学
蛋白别名: Nuclear envelope pore membrane protein POM 121; Nuclear envelope pore membrane protein POM 121A; nuclear pore membrane glycoprotein 121 kD; nuclear pore membrane protein 121; nuclear pore membrane protein 121 kDa; nuclear pore membrane protein 121-2; Nucleoporin Nup121; P145; POM121 membrane glycoprotein; POM121 membrane glycoprotein C; POM121B; Pore membrane protein of 121 kDa; pore membrane protein of 121 kDa C; unnamed protein product
基因别名: 2610027A18Rik; C80273; KIAA0618; mKIAA0618; NUP121; P145; POM121; POM121-2; POM121A
UniProt ID: (Human) Q96HA1, (Rat) P52591, (Mouse) Q8K3Z9
Entrez Gene ID: (Human) 9883, (Human) 100101267, (Rat) 113975, (Mouse) 107939